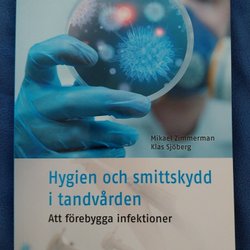

Sluttid6 mar 18:39.
Pris:69 kr,Köp nu.
Sluttid11 feb 14:08.
Pris:35 kr,Utropspris.
Sluttid17 feb 12:47.
Pris:190 kr,Eller Köp nu 200 kr,.
Sluttid11 feb 11:47.
Pris:28 kr,Utropspris.
Sluttid17 feb 20:15.
Pris:20 kr,Eller Köp nu 24 kr,.
Sluttid5 mar 20:06.
Pris:50 kr,Köp nu.
Sluttid5 mar 18:36.
Pris:79 kr,Köp nu.
Sluttid9 feb 17:47.
Pris:210 kr,Eller Köp nu 350 kr,.
Sluttid10 feb 17:24.
Pris:10 kr,Utropspris.
Sluttid10 feb 19:31.
Pris:79 kr,Utropspris.
Sluttid4 mar 23:14.
Pris:349 kr,Köp nu.
Sluttid16 feb 20:27.
Pris:75 kr,Eller Köp nu 150 kr,.
Sluttid9 feb 20:19.
Pris:79 kr,Utropspris.
Sluttid9 feb 20:16.
Pris:79 kr,Utropspris.
Sluttid9 feb 20:09.
Pris:99 kr,Utropspris.
Sluttid8 feb 19:43.
Pris:100 kr,Eller Köp nu 105 kr,.
Sluttid9 feb 18:00.
Pris:79 kr,Utropspris.
Sluttid4 mar 18:53.
Pris:45 kr,Köp nu.
Sluttid9 feb 18:38.
Pris:129 kr,Utropspris.
Sluttid8 feb 17:56.
Pris:40 kr,Utropspris.
Sluttid8 feb 21:58.
Pris:20 kr,Eller Köp nu 60 kr,.
Sluttid4 mar 15:48.
Pris:90 kr,Köp nu.
Sluttid8 feb 09:12.
Pris:405 kr,Utropspris.
Sluttid4 mar 08:08.
Pris:425 kr,Köp nu.
Sluttid8 feb 20:23.
Pris:49 kr,Eller Köp nu 99 kr,.
Sluttid8 feb 20:01.
Pris:350 kr,Eller Köp nu 400 kr,.
Sluttid8 feb 19:37.
Pris:129 kr,Eller Köp nu 139 kr,.
Sluttid3 mar 19:22.
Pris:99 kr,Köp nu.
Sluttid3 mar 19:18.
Pris:79 kr,Köp nu.
Sluttid8 feb 18:47.
Pris:59 kr,Utropspris.
Sluttid12 feb 15:17.
Pris:199 kr,Eller Köp nu 250 kr,.
Sluttid8 feb 12:52.
Pris:5 kr,Eller Köp nu 10 kr,.
Sluttid8 feb 12:01.
Pris:89 kr,Utropspris.
Sluttid2 mar 22:48.
Pris:65 kr,Köp nu.
Sluttid8 feb 20:48.
Pris:75 kr,Utropspris.
Sluttid2 mar 13:35.
Pris:10 kr,Köp nu.